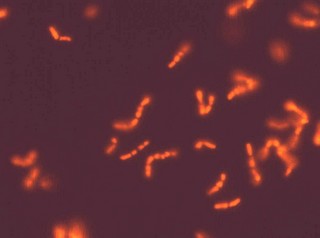

BioVisible
is active in Research and Development, analysis services, production and commercialisation of Molecular Microbial Diagnostics for the detection and identification of micro organisms using a variety of molecular approaches like, FISH, DGGE or TGGE, Q-PCR or real time PCR, DNA micro array, NASBA, NGS or other molecular techniques.
Gut microflora analysis services of BioVisible
BioVisible offers a unique analysis service for the evaluation of the effects of probiotics and prebiotics on Gut microflora using FISH (fluorescence in situ hybridization), (T)DGGE ((Temperature)Denaturing Gradient Gel Electrophoresis), Real-time PCR and/or NGS. Please contact us for more information
Contract Research & Development
BioVisible develops, tailor-made, advanced diagnostic tests based on DNA/RNA technology.
.jpg)
.jpg)
.jpg)
.jpg)
.jpg)
.jpg)
.jpg)
.jpg)
.jpg)
.jpg)
.jpg)
.jpg)
.jpg)
.jpg)
.jpg)
.jpg)
.jpg)
.jpg)
.jpg)
.jpg)
.jpg)
.jpg)
.jpg)
.jpg)
.jpg)
.jpg)
.jpg)
.jpg)
.jpg)
.jpg)
.jpg)
.jpg)
.jpg)
.jpg) Z-Stackimage; Stomach lining, Total bacteria FITC, probably Helicobacter pylori.
Courtesy of the Medizinische Hochschule Hannover, Germany.
Z-Stackimage; Stomach lining, Total bacteria FITC, probably Helicobacter pylori.
Courtesy of the Medizinische Hochschule Hannover, Germany.
Products

FISH fotopage
Some examples of FISH images

Background FISH
The detection of whole-bacterial cells via the labelling of specific nucleic acids with fluorescently labelled oligonucleotide probes is called fluorescence in situ hybridization (FISH)

Background T(D)GGE
Temperature Gradient Gel Electrophoresis (TGGE)or Denaturing Gradient Gel Electrophoresis (DGGE) is a molecular fingerprinting method that separates polymerase chain reaction (PCR)-generated DNA products.
Background References
List of references detailing the use of FISH, T(D)GGE and the Mitochondrial toxicity test